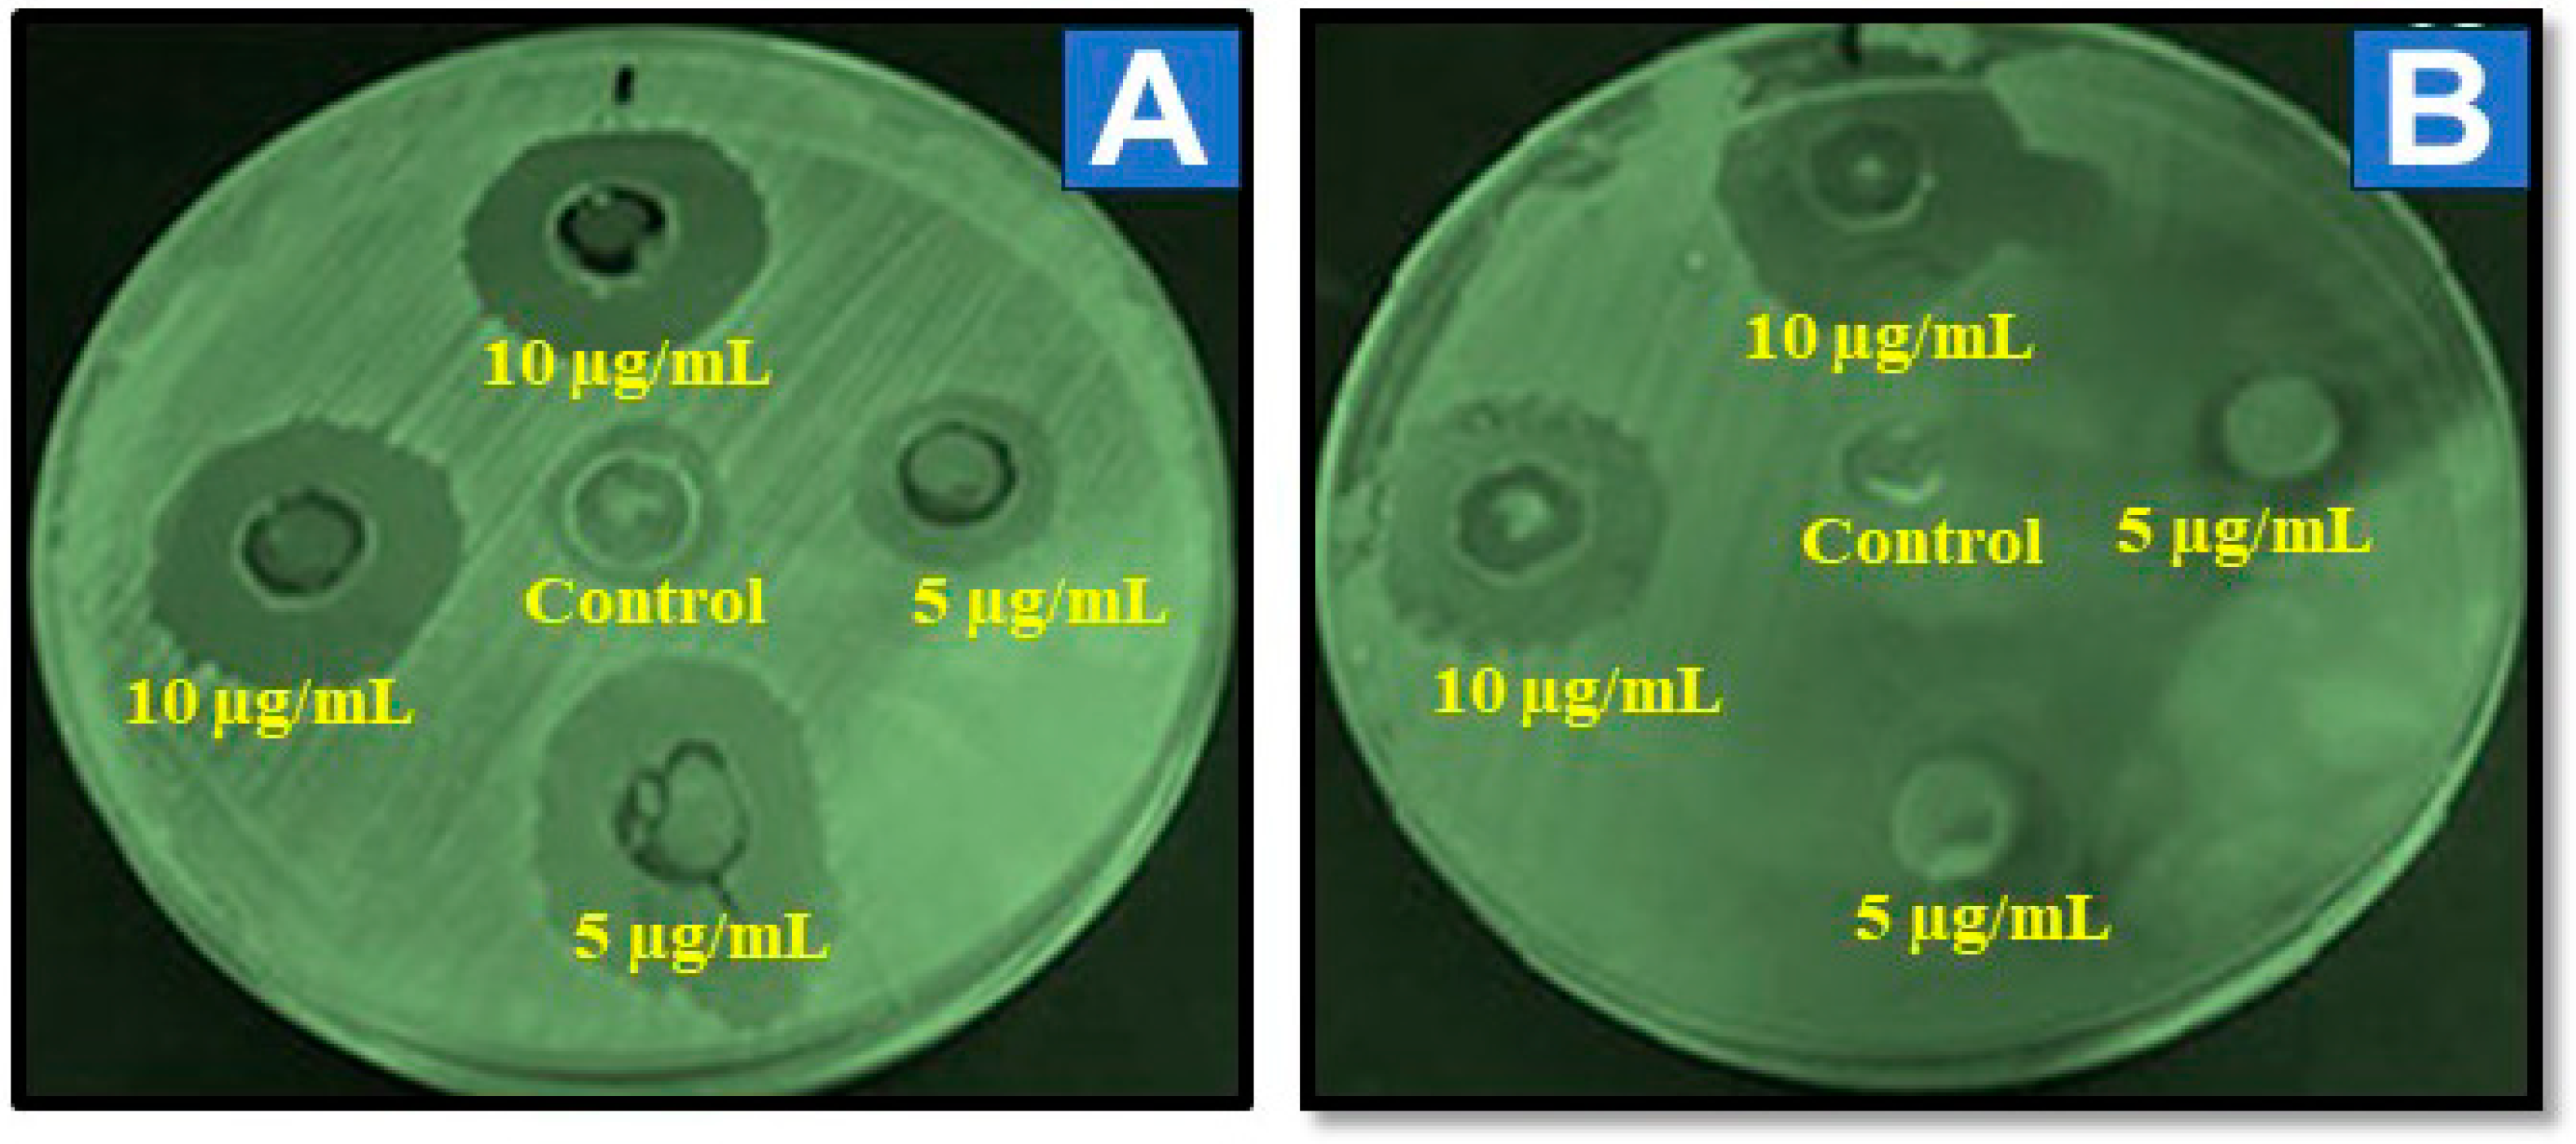
Nanomaterials 14 01851 g008

Green Synthesis of Al-ZnO Nanoparticles Using Cucumis maderaspatanus Plant Extracts: Analysis of Structural, Antioxidant, and Antibacterial Activities
Abstract
1. Introduction
2. Materials and Methods
2.1. Materials
2.2. Preparation of Cucumis maderaspatanus Leaf Extracts
2.3. Green Synthesis of Al-ZnO Nanoparticles Using Cucumis maderaspatanus
2.4. Characterization of Al-ZnO Nanoparticles
2.4.1. UV-Vis Spectroscopy Analysis
2.4.2. FOURIER Transform Infrared Spectroscopy (FTIR) Analysis
2.4.3. X-Ray Diffraction (XRD) Analysis
2.4.4. Scanning Electron Microscopy (SEM) Analysis
2.4.5. Transmission Electron Microscopy (TEM) Analysis
2.4.6. Dynamic Light Scattering, and Zeta Potential Analysis
2.4.7. Thermogravimetric Analysis (TGA)
2.4.8. Antibacterial Activity Studies
2.4.9. Antioxidant Activity Studies
3. Results and Discussion
3.1. Structural and Morphological Studies
3.2. FTIR Analysis
3.3. Optical Studies
3.4. Dynamic Light Scattering and Zeta-Potential Analysis
3.5. Thermal Analysis
3.6. Biological Studies of Al-ZnO Nanoparticles Utilizing Cucumis maderaspatanus Leaf Extracts
3.6.1. Antibacterial Activity
3.6.2. Antifungal Activity
3.6.3. Antioxidant Activity
4. Conclusions
Author Contributions
Funding
Data Availability Statement
Acknowledgments
Conflicts of Interest
References
- Bhardwaj, B.; Singh, P.; Kumar, A.; Kumar, S.; Budhwar, V. Eco-friendly greener synthesis of nanoparticles. Adv. Pharm. Bull. 2020, 10, 566. [Google Scholar] [CrossRef] [PubMed]
- Ying, S.; Guan, Z.; Ofoegbu, P.C.; Clubb, P.; Rico, C.; He, F.; Hong, J. Green synthesis of nanoparticles: Current developments and limitations. Environ. Technol. Innov. 2022, 26, 102336. [Google Scholar] [CrossRef]
- Kumar, J.A.; Krithiga, T.; Manigandan, S.; Sathish, S.; Renita, A.A.; Prakash, P.; Prasad, B.N.; Kumar, T.P.; Rajasimman, M.; Hosseini-Bandegharaei, A.; et al. A focus to green synthesis of metal/metal-based oxide nanoparticles: Various mechanisms and applications towards ecological approach. J. Clean. Prod. 2021, 324, 29198. [Google Scholar] [CrossRef]
- Dey, S.; Mohanty, D.L.; Divya, N.; Bakshi, V.; Mohanty, A.; Rath, D.; Das, S.; Mondal, A.; Roy, S.; Sabuli, R. A critical review on zinc oxide nanoparticles: Synthesis, properties and biomedical applications. Intell. Pharm. 2024. [Google Scholar] [CrossRef]
- Patil, S.; Jagadale, S. Co-precipitation methods for the synthesis of metal oxide nanostructures. In Solution Methods for Metal Oxide Nanostructures; Elsevier: Amsterdam, The Netherlands, 2023; pp. 39–60. [Google Scholar]
- Chan, Y.Y.; Pang, Y.L.; Lim, S.; Chong, W.C. Facile green synthesis of ZnO nanoparticles using natural-based materials: Properties, mechanism, surface modification and application. J. Environ. Chem. Eng. 2021, 9, 105417. [Google Scholar] [CrossRef]
- Alhalili, Z. Metal oxides nanoparticles: General structural description, chemical, physical, and biological synthesis methods, role in pesticides and heavy metal removal through wastewater treatment. Molecules 2023, 28, 3086. [Google Scholar] [CrossRef]
- Attar, U.A.; Ghane, S.G. Proximate composition, ionomics, phytochemical, antioxidant, anti-diabetic and acetylcholinesterase inhibitory activity of Cucumis species from western ghats of India. Indian J. Pharm. Sci. 2021, 83, 679–694. [Google Scholar] [CrossRef]
- Khan, A.; Mishra, A.; Hasan, S.M.; Usmani, A.; Ubaid, M.; Khan, N.; Saidurrahman, M. Biological and medicinal application of Cucumissativus Linn.—Review of current status with future possibilities. J. Complement. Integr. Med. 2022, 19, 843–854. [Google Scholar] [CrossRef] [PubMed]
- Gurusamy, M.; Sellavel, M.; Kuppuvelsamy, V. A sustainable green synthesis for photocatalytic and antibacterial activity of zinc oxide nanoparticles using Cucumis maderaspatanus leaf extract. Desalination Water Treat. 2024, 319, 100457. [Google Scholar] [CrossRef]
- Rakholiya, K.; Kaneria, M.; Chanda, S. Inhibition of microbial pathogens using fruit and vegetable peel extracts. Int. J. Food Sci. Nutr. 2014, 65, 733–739. [Google Scholar] [CrossRef]
- Shalaby, M.A.; Anwar, M.M.; Saeed, H. Nanomaterials for application in wound healing: Current state-of-the-art and future perspectives. J. Polym. Res. 2022, 29, 91. [Google Scholar] [CrossRef]
- Raja, R.D.A.; Jeeva, S.; Prakash, J.W.; Antonisamy, J.M.; Irudayaraj, V. Antibacterial activity of selected ethnomedicinal plants from South India. Asian Pac. J. Trop. Med. 2011, 4, 375–378. [Google Scholar] [CrossRef] [PubMed]
- Karam, S.T.; Abdulrahman, A.F. Green synthesis and characterization of ZnO nanoparticles by using thyme plant leaf extract. Photonics 2022, 9, 594. [Google Scholar] [CrossRef]
- Mendes, C.R.; Dilarri, G.; Forsan, C.F.; Sapata, V.M.R.; Lopes, P.R.M.; Moraes, P.B.; Montagnolli, R.N.; Ferreira, H.; Bidoia, E.D. Antibacterial action and target mechanisms of zinc oxide nanoparticles against bacterial pathogens. Sci. Rep. 2022, 12, 2658. [Google Scholar] [CrossRef] [PubMed]
- Mehrabanpour, N.; Nezamzadeh-Ejhieh, A.; Ghattavi, S. A comparative photocatalytic activity between PbS NPs and PbS-clinoptilolite towards Cefotaxime. Solid State Sci. 2022, 131, 106953. [Google Scholar] [CrossRef]
- Hosny, N.M.; Gomaa, I.; Elmahgary, M.G.; Ibrahim, M.A. ZnO doped C: Facile synthesis, characterization and photocatalytic degradation of dyes. Sci. Rep. 2023, 13, 14173. [Google Scholar] [CrossRef]
- Ghramh, H.A.; Ibrahim, E.H.; Kilnay, M.; Ahmad, Z.; Alhag, S.K.; Khan, K.A.; Taha, R.; Asiri, F.M. Silver nanoparticle production by Rutagraveolens and testing its safety, bioactivity, immune modulation, anticancer, and insecticidal potentials. Bioinorg. Chem. Appl. 2020, 2020, 5626382. [Google Scholar] [CrossRef]
- Porrawatkul, P.; Nuengmatcha, P.; Kuyyogsuy, A.; Pimsen, R.; Rattanaburi, P. Effect of Na and Al doping on ZnO nanoparticles for potential application in sunscreens. J. Photochem. Photobiol. B Biol. 2023, 240, 112668. [Google Scholar] [CrossRef]
- Mishra, P.N.; Mishra, P.K.; Pathak, D. The influence of Al doping on the optical characteristics of ZnO nanopowders obtained by the low-cost sol-gel method. Chemistry 2022, 4, 1136–1146. [Google Scholar] [CrossRef]
- Carofiglio, M.; Barui, S.; Cauda, V.; Laurenti, M. Doped zinc oxide nanoparticles: Synthesis, characterization and potential use in Nano medicine. Appl. Sci. 2020, 10, 5194. [Google Scholar] [CrossRef]
- Dorcas, M.; Taziwa, R.; Khotseng, L.E. A review of the green synthesis of ZnO nanoparticles utilizing Southern African indigenous medicinal plants. Nanomaterials 2022, 12, 3456. [Google Scholar]
- Akbari, B.; Tavandashti, M.P.; Zandrahimi, M. Particle size characterization of nanoparticles—A practical approach. Iran. J. Mater. Sci. Eng. 2011, 8, 48–56. [Google Scholar]
- Bhuiyan, M.R.A.; Alam, M.M.; Momin, M.A.; Mamur, H. Characterization of Al doped ZnO nanostructures via an electrochemical route. Int. J. Energy Appl. Technol. 2017, 4, 28–33. [Google Scholar]
- Jeevarathinam, M.; Asharani, I.V. Synthesis of CuO, ZnO nanoparticles, and CuO-ZnO nanocomposite for enhanced photocatalytic degradation of Rhodamine B: A comparative study. Sci. Rep. 2024, 14, 9718. [Google Scholar] [CrossRef]
- Khoshhesab, Z.M.; Sarfaraz, M.; Asadabad, M.A. Preparation of ZnO nanostructures by chemical precipitation method. Synth. React. Inorg. Met.-Org. Nano-Met. Chem. 2011, 41, 814–819. [Google Scholar] [CrossRef]
- Petrov, V.V.; Ignatieva, I.O.; Volkova, M.G.; Gulyaeva, I.A.; Pankov, I.V.; Bayan, E.M. Polycrystalline transparent Al-doped ZnO thin films for photosensitivity and optoelectronic applications. Nanomaterials 2023, 13, 2348. [Google Scholar] [CrossRef]
- Bagabas, A.; Alshammari, A.; Aboud, M.F.A.; Kosslick, H. Room-temperature synthesis of zinc oxide nanoparticles in different media and their application in cyanide photo degradation. Nanoscale Res. Lett. 2013, 8, 516. [Google Scholar] [CrossRef]
- Aguilar-Ferrer, D.; Szewczyk, J.; Coy, E. Recent developments in polydopamine-based photocatalytic nanocomposites for energy production: Physico-chemical properties and perspectives. Catal. Today 2022, 397, 316–349. [Google Scholar] [CrossRef]
- Raj, R.; Gupta, H.; Purohit, L.P. Highly transparent and conducting Al-doped ZnO as a promising material for optoelectronic applications. Pramana 2021, 95, 87. [Google Scholar] [CrossRef]
- Ismail, E.H.; Sabry, D.Y.; Mahdy, H.; Khalil, M.M. Synthesis and characterization of some ternary metal complexes of curcumin with 1,10-phenanthroline and their anticancer applications. J. Sci. Res. 2014, 6, 509–519. [Google Scholar] [CrossRef]
- Degefa, A.; Bekele, B.; Jule, L.T.; Fikadu, B.; Ramaswamy, S.; Dwarampudi, L.P.; Nagaprasad, N.; Ramaswamy, K. Green synthesis, characterization of zinc oxide nanoparticles, and examination of properties for dye-sensitive solar cells using various vegetable extracts. J. Nanomater. 2021, 2021, 3941923. [Google Scholar] [CrossRef]
- Wang, X.C.; Chen, X.M.; Yang, B.H. Microstructure and optical properties of polycrystalline ZnO films sputtered under different oxygen flow rates. J. Alloys Compd. 2009, 488, 232–237. [Google Scholar] [CrossRef]
- Zak, A.K.; Abrishami, M.E.; Abd Majid, W.H.; Yousefi, R.; Hosseini, S.M. Effects of annealing temperature on some structural and optical properties of ZnO nanoparticles prepared by a modified sol–gel combustion method. Ceram. Int. 2011, 37, 393–398. [Google Scholar] [CrossRef]
- Rishikeshi, S.N.; Joshi, S. Cu–ZnO nanocrystallites by aqueous thermolysis method. J. Therm. Anal. Calorim. 2012, 109, 1473–1479. [Google Scholar] [CrossRef]
- Tien, C.H.; Kuo, C.H.; Wuu, D.S.; Horng, R.H. Improved optoelectronic performance of high-voltage ultraviolet light-emitting diodes through electrode designs. IEEE Trans. Electron Devices 2017, 64, 4526–4531. [Google Scholar] [CrossRef]
- Arias, A.; Feijoo, G.; Moreira, M.T. Exploring the potential of antioxidants from fruits and vegetables and strategies for their recovery. Innov. Food Sci. Emerg. Technol. 2022, 77, 102974. [Google Scholar] [CrossRef]
- El-Naggar, M.; Mohamed, M.E.; Mosallam, A.M.; Salem, W.; Rashdan, H.R.; Abdelmonsef, A.H. Synthesis, characterization, antibacterial activity, and computer-aided design of novel Quinazolin-2,4-dione derivatives as potential inhibitors against Vibrio cholerae. Evol. Bioinform. 2020, 16, 1–13. [Google Scholar] [CrossRef]
- Rekha, K.; Nirmala, M.; Nair, M.G.; Anukaliani, A. Structural, optical, photocatalytic and antibacterial activity of zinc oxide and manganese doped zinc oxide nanoparticles. Phys. B Condens. Matter 2010, 405, 3180–3185. [Google Scholar] [CrossRef]
- Nikoobakht, B.; El-Sayed, M.A. Preparation and growth mechanism of gold nanorods (NRs) using seed-mediated growth method. Chem. Mater. 2003, 15, 1957–1962. [Google Scholar] [CrossRef]
- Cervantes-Gaxiola, M.E.; Vázquez-González, F.A.; Rios-Iribe, E.Y.; Méndez-Herrera, P.F.; Leyva, C. Effect of pH on the green synthesis of ZnO nanoparticles using Sorghum bicolor seed extract and their application in photocatalytic dye degradation. Mater. Lett. 2024, 372, 136982. [Google Scholar] [CrossRef]
- Hussain, S.; Khakwani, N.; Faiz, N.; Zulfiqar, S.; Shafiq, Z.; Faiz, F.; Elhakem, A.; Sami, R.; Aljuraide, N.I.; Farid, T.; et al. Green production and interaction of carboxylated CNTs/biogenic ZnO composite for antibacterial activity. Bioengineering 2022, 9, 437. [Google Scholar] [CrossRef] [PubMed]
- Yang, H.; Zhang, J.; Li, Z.; Huang, J.; Wu, J.; Zhang, Y.; Ge, H.; Zhao, Y. Antibacterial effect of low-concentration ZnO nanoparticles on sulfate-reducing bacteria under visible light. Nanomaterials 2023, 13, 2033. [Google Scholar] [CrossRef]
- Arciniegas-Grijalba, P.A.; Patiño-Portela, M.C.; Mosquera-Sánchez, L.P.; Guerrero-Vargas, J.A.; Rodríguez-Páez, J.E. ZnO nanoparticles (ZnO-NPs) and their antifungal activity against coffee fungus Erythricium salmonicolor. Appl. Nanosci. 2017, 7, 225–241. [Google Scholar] [CrossRef]
- Lopes, J.P.; Lionakis, M.S. Pathogenesis and virulence of Candida albicans. Virulence 2022, 13, 89–121. [Google Scholar] [CrossRef] [PubMed]
- García-López, J.I.; Zavala-García, F.; Olivares-Sáenz, E.; Lira-Saldívar, R.H.; DíazBarriga-Castro, E.; Ruiz-Torres, N.A.; Ramos-Cortez, E.; Vázquez-Alvarado, R.; Niño-Medina, G. Zinc oxide nanoparticles boost phenolic compounds and antioxidant activity of Capsicum annuum L. during germination. Agronomy 2018, 8, 215. [Google Scholar] [CrossRef]
- Juan, C.A.; Lastra, J.M.P.; Plou, F.J.; Pérez-Lebeña, E. The chemistry of reactive oxygen species (ROS) revisited: Outlining their role in biological macromolecules (DNA, lipids and proteins) and induced pathologies. Int. J. Mol. Sci. 2021, 22, 4642. [Google Scholar] [CrossRef]
- Shan, F.K.; Yu, Y.S. Band gap energy of pure and Al-doped ZnO thin films. J. Eur. Ceram. Soc. 2004, 24, 1869–1872. [Google Scholar] [CrossRef]
- Sugitha, S.K.J.; Latha, R.G.; Venkatesan, R.; Vetcher, A.A.; Ali, N.; Kim, S.-C. Biological effects of green synthesized Al-ZnO nanoparticles using leaf extract from Anisomeles indica (L.) Kuntze on living organisms. Nanomaterials 2024, 14, 1407. [Google Scholar] [CrossRef] [PubMed]
- Sugitha, S.K.J.; Venkatesan, R.; Latha, R.G.; Vetcher, A.A.; Al-Asbahi, B.A.; Kim, S.-C. A Study on the antibacterial, antispasmodic, antipyretic, and anti-inflammatory activity of ZnO nanoparticles using leaf extract from Jasminum sambac (L. Aiton). Molecules 2024, 29, 1464. [Google Scholar] [CrossRef]
- Priya, M.; Venkatesan, R.; Deepa, S.; Sana, S.S.; Arumugam, S.; Karami, A.M.; Vetcher, A.A.; Kim, S.-C. Green synthesis, characterization, antibacterial, and antifungal activity of copper oxide nanoparticles derived from Morinda citrifolia leaf extract. Sci. Rep. 2023, 13, 18838. [Google Scholar] [CrossRef]
- Sukumaran, J.; Venkatesan, R.; Priya, M.; Kim, S.-C. Eco-friendly synthesis of CeO2 nanoparticles using Morinda citrifolia L. leaf extracts: Evaluation of structural, antibacterial, and anti-inflammatory activity. Inorg. Chem. Commun. 2024, 170, 113411. [Google Scholar] [CrossRef]

| S. No | Name of the Organisms | Zone of Inhibition (mm-cm) | Positive Control | |
|---|---|---|---|---|
| 5 mg/mL | 10 mg/mL | |||
| 1. | K. bacillus | 1.05 ± 0.02 | 2.65 ± 0.15 | 4.60 ± 0.07 |
| 2. | E. coli | NA | NA | 2.10 ± 0.01 |
| 3. | V. cholera | 1.10 ± 0.01 | 1.98 ± 0.03 | NA |
| 4. | B. subtilis | 0.44 ± 0.08 | 1.01 ± 0.01 | 3.25 ± 0.01 |
| 5. | S. aureus | 2.63 ± 0.02 | 4.01 ± 0.01 | 4.00 ± 0.02 |
| 6. | S. mutans | NA | 0.67 ± 0.01 | 4.20 ± 0.34 |
| Name of the Organisms | Resistant Zone (mm-cm) | Positive Control | |
|---|---|---|---|
| 5 mg/mL | 10 mg/mL | ||
| Aspergillus flavus | 0.73 ± 0.04 | 1.25 ± 0.01 | 3.00 ± 0.00 |
| Candida albicans | NA | NA | 2.50 ± 0.61 |
| S. No | Concentration (mg/mL) | Antioxidant Activity of % of Inhibition | Standard |
|---|---|---|---|
| 1. | 0.2 | 32.8 | Ascorbic acid is used as a standard |
| 2. | 0.4 | 38.9 | |
| 3. | 0.6 | 45.3 | |
| 4. | 0.8 | 51.2 | |
| 5. | 1.0 | 61.0 |
Disclaimer/Publisher’s Note: The statements, opinions and data contained in all publications are solely those of the individual author(s) and contributor(s) and not of MDPI and/or the editor(s). MDPI and/or the editor(s) disclaim responsibility for any injury to people or property resulting from any ideas, methods, instructions or products referred to in the content. |
© 2024 by the authors. Licensee MDPI, Basel, Switzerland. This article is an open access article distributed under the terms and conditions of the Creative Commons Attribution (CC BY) license (https://creativecommons.org/licenses/by/4.0/).
Share and Cite
Sugitha, S.K.J.; Latha, R.G.; Venkatesan, R.; Kim, S.-C.; Vetcher, A.A.; Khan, M.R. Green Synthesis of Al-ZnO Nanoparticles Using Cucumis maderaspatanus Plant Extracts: Analysis of Structural, Antioxidant, and Antibacterial Activities. Nanomaterials 2024, 14, 1851. https://doi.org/10.3390/nano14221851
Sugitha SKJ, Latha RG, Venkatesan R, Kim S-C, Vetcher AA, Khan MR. Green Synthesis of Al-ZnO Nanoparticles Using Cucumis maderaspatanus Plant Extracts: Analysis of Structural, Antioxidant, and Antibacterial Activities. Nanomaterials. 2024; 14(22):1851. https://doi.org/10.3390/nano14221851
Chicago/Turabian StyleSugitha, S. K. Johnsy, R. Gladis Latha, Raja Venkatesan, Seong-Cheol Kim, Alexandre A. Vetcher, and Mohammad Rashid Khan. 2024. "Green Synthesis of Al-ZnO Nanoparticles Using Cucumis maderaspatanus Plant Extracts: Analysis of Structural, Antioxidant, and Antibacterial Activities" Nanomaterials 14, no. 22: 1851. https://doi.org/10.3390/nano14221851
APA StyleSugitha, S. K. J., Latha, R. G., Venkatesan, R., Kim, S.-C., Vetcher, A. A., & Khan, M. R. (2024). Green Synthesis of Al-ZnO Nanoparticles Using Cucumis maderaspatanus Plant Extracts: Analysis of Structural, Antioxidant, and Antibacterial Activities. Nanomaterials, 14(22), 1851. https://doi.org/10.3390/nano14221851

